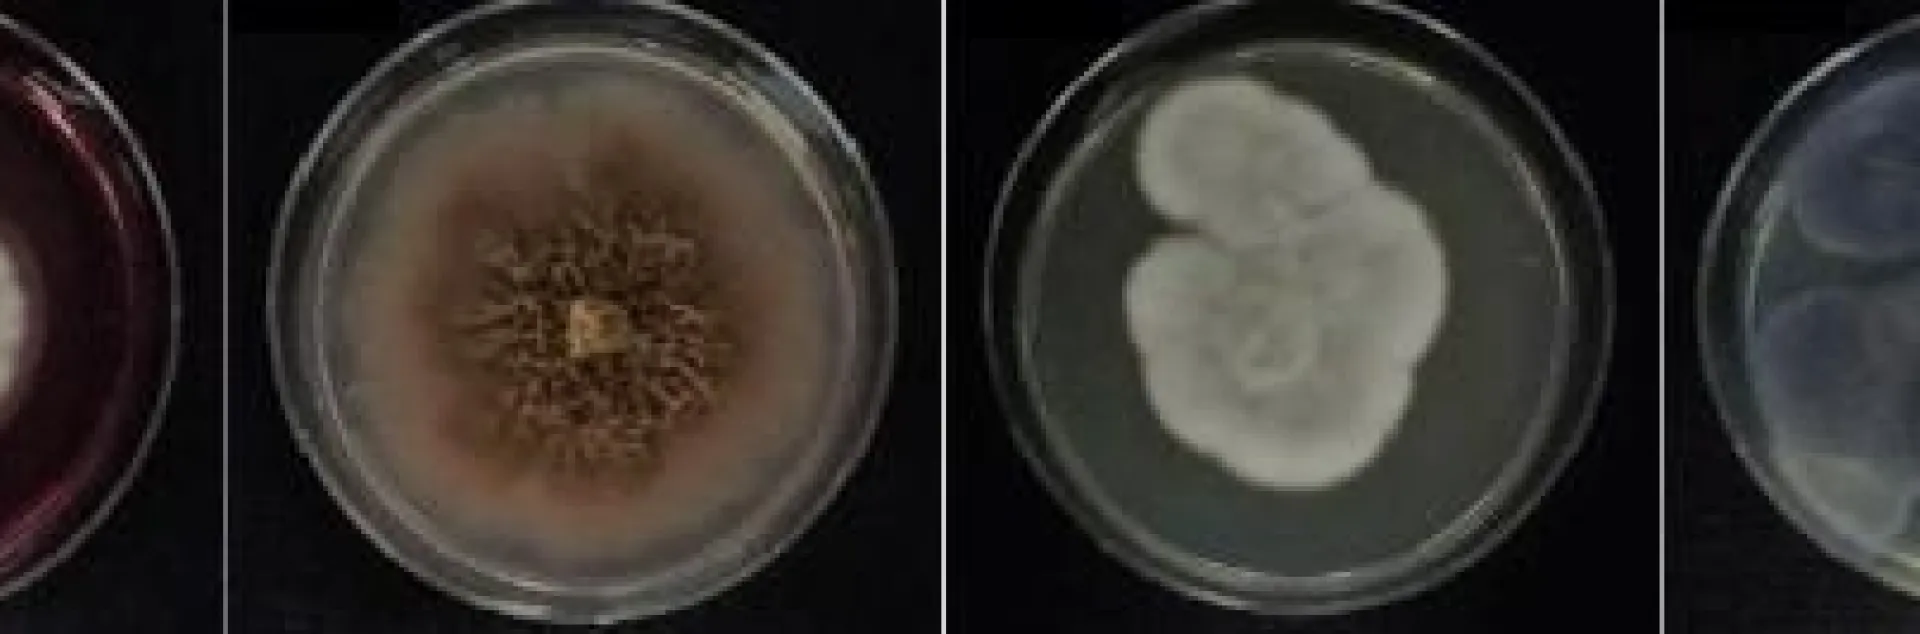

Antarctic fungi found to be effective against citrus canker
Brazilian researchers have identified activity against Xanthomonas citri in 29 fungi isolated from samples collected in Antarctica; one of the compounds inhibited reproduction of the bacterium by up to 98 percent
A research team at the São Paulo State University's Bioscience Institute (IB-UNESP) in Rio Claro, Brazil, has identified 29 fungi with proven action against Xanthomonas citri, a bacterium responsible for citrus canker, an endemic disease in all citrus-producing countries. The origin of the fungi is surprising. They were isolated from samples of soil and marine sediment collected in Antarctica.
"These fungi live in isolated conditions and proliferate under inhospitable conditions including low temperatures and high levels of ultraviolet radiation," says Daiane Cristina Sass, a Professor at UNESP who heads a project engaged in a search for microorganisms that produce compounds with antibacterial action for use in agriculture, with support from the São Paulo Research Foundation - FAPESP.
"How have they adapted to survive in an environment so hostile to life? We wanted to see if they produced molecules with unique structures that protected them from infections and might therefore be capable of antibacterial action." Sass wrote an article published in Letters in Applied Microbiology - jointly with IB-UNESP colleagues Lara Durães Sette and Henrique Ferreira, among others - which shows some of the research's results.
More efficiency on fighting citrus canker
Although the bacterium can be combated in several ways, none is sufficient to eradicate the disease. Therefore, new chemical or biological methods of protecting citrus groves have to be pursued.
The disease is controlled directly by growers. The recommended measures include spraying trees with copper-based products and replacing infected trees with healthy new plantings derived from more resistant varieties. Control of the citrus leaf miner (Phyllocnistis citrella) is also advisable. The wounds made by larvae of this moth in feeding on the plant exacerbate citrus canker by serving as an entry point for X. citri.
"The main method for combating citrus canker consists of spraying trees with copper compounds. The downside is that when even small amounts are used for a long period, copper accumulates in the fruit, soil and water, eventually contaminating the entire environment. For this reason, we're looking for new compounds that are less aggressive to the environment and also less harmful to humans," Sass explained.
Collection and isolation of the Antarctic fungi
On the extent of the Sass-headed project and its research on biotechnology, the team came up with the idea of investigating the collection of fungi curated by Professor Sette, which resulted from Antarctic summer expeditions to the South Shetland Islands in 2013 and 2015 as part of Project Microsfera, conducted under the aegis of the Brazilian Antarctic Program (PROANTAR) and sponsored by the National Council for Scientific & Technological Development (CNPq).
Sette leads the project "Marine and Antarctic mycology: diversity and environmental application", also supported by FAPESP.
Sette isolated 33 filamentous fungi from samples collected in soil under rotten wood on Deception Island and 53 filamentous fungi from marine sediments at a depth of 20 meters in Admiralty Bay, King George Island. All fungal strains are kept at UNESP's Microbial Resource Center (CRM).
The FAPESP-funded research found that 29 of the 86 Antarctic fungi they isolated (19 of marine origin and ten terrestrial) contained compounds with proven action against X. citri.
Isolating the compounds produced by the fungi and verifying their antibacterial activity involved several stages. The process began with isolation of the fungi, which were then grown for several days in culture dishes with nutrients.
The fungi were cultured in liquid medium and shaken for 20 days at 15 °C. The solid biomass was separated from the liquid portion, and both parts were submitted to processing with solvents to obtain intracellular and extracellular extracts.
Tests
The researchers obtained 158 extracts. Each extract was diluted at several concentrations (2.10 mg/ml-0.02 mg/ml) and tested against X. citri. In the case of the soil fungi, most of the extracts with antibacterial action were intracellular in origin, while for the marine fungi, only the extracellular extracts hindered the bacterium's growth.
"We wanted to determine the lowest concentration of each extract that inhibited growth in 90% of cases," Sass said.
Some (12) of the extracts affected bacterial growth at lower concentrations than the highest tested, and ten of these inhibited growth in more than 90% of cases at concentrations of 1.5 mg/ml-1.0 mg/ml.
"At maximum concentration, one extract inhibited growth by up to 98%, and another inhibited it by about 80% at 0.52 mg/ml," Sass said. "It's important to note that we're talking about extracts [which contain varying amounts of molecules]. If an extract contains only one compound that's responsible for this bioactivity, the compound may display good antibacterial activity at much lower concentrations."
Twenty of the isolated fungi with action against X. citri belonged to the genus Pseudogymnoascus and were extracted from terrestrial and marine samples. Next came Penicillium (five), followed by Cadophora (two), Paraconiothyrium (one) and Toxicocladosporium (one), all extracted from marine sediments.
Having identified the extracts with action against X. citri, the researchers are now working to find out which chemical compounds give them this antibacterial capability.
"We expect to identify and purify some of these bioactive compounds, as well as to complete toxicology testing on them, within 18 months or less," Sass said.
The researchers plan to patent the compounds they identify. They also hope to persuade pesticide manufacturers to develop commercial products for combating citrus canker based on these compounds.
https://www.eurekalert.org/pub_releases/2018-06/fda-aff061318.php
Twenty of the isolated fungi with action against X. citri belonged to the genus Pseudogymnoascus and were extracted from terrestrial and marine samples. Next came Penicillium (five), followed by Cadophora (two), Paraconiothyrium (one) and Toxicocladosporium (one), all extracted from marine sediments.